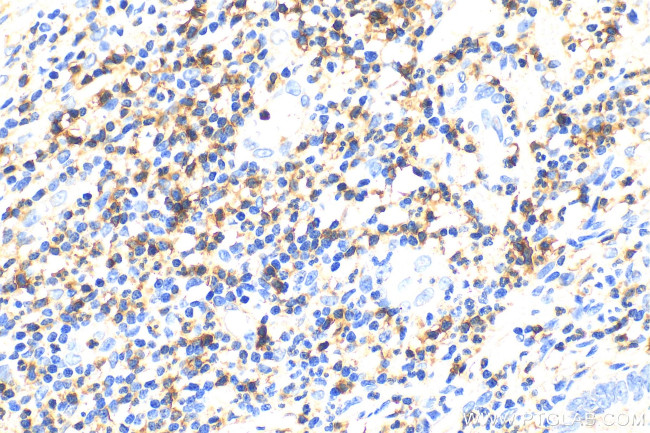
CD5 Antibody in Immunohistochemistry (Paraffin) (IHC (P))

Search
Proteintech
CD5 Polyclonal Antibody
{{$productOrderCtrl.translations['antibody.pdp.commerceCard.promotion.promotions']}}
{{$productOrderCtrl.translations['antibody.pdp.commerceCard.promotion.viewpromo']}}
{{$productOrderCtrl.translations['antibody.pdp.commerceCard.promotion.promocode']}}: {{promo.promoCode}} {{promo.promoTitle}} {{promo.promoDescription}}. {{$productOrderCtrl.translations['antibody.pdp.commerceCard.promotion.learnmore']}}
产品信息
31502-1-AP
种属反应
宿主/亚型
分类
类型
抗原
偶联物
形式
浓度
纯化类型
保存液
内含物
保存条件
运输条件
靶标信息
CD5 is a 67 kDa human T-lymphocyte single-chain transmembrane glycoprotein. CD5 is present on all mature T-lymphocytes, on most of thymocytes and on many T-cell leukemias and lymphomas. CD5 also reacts with a subpopulation of activated B-cells and may act as a receptor in regulating T-cell proliferation. CD5 is found on 95% of thymocytes and 72% of peripheral blood lymphocytes. In lymph nodes, the main reactivity is observed in T cell areas. CD5 is expressed by many T cell leukemia, lymphomas, and activated T cells. Diseases associated with CD5 dysfunction include thymus cancer and Richter's Syndrome.
仅用于科研。不用于诊断过程。未经明确授权不得转售。
篇参考文献 (0)
生物信息学
蛋白别名: CD antigen CD5; CD5; CD5 antigen (p56 62); CD5 antigen (p56-62); CD5 antigen p56-62; fCD5; Ly12; LyA; Lymphocyte antigen T1/Leu-1; Pan T cell; T-cell surface glycoprotein CD5
基因别名: CD5; LEU1; T1
UniProt ID: (Human) P06127
Entrez Gene ID: (Human) 921